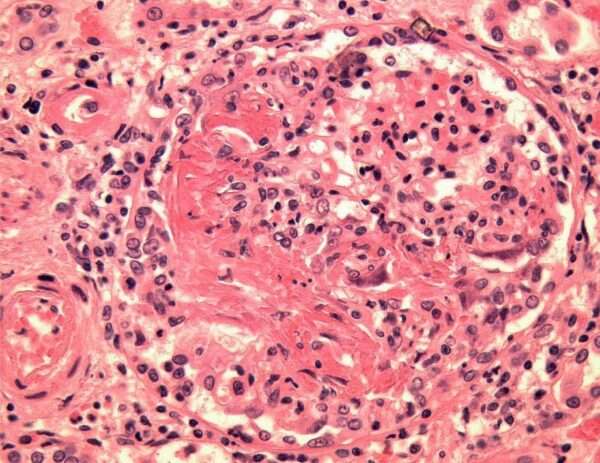
Poliangiitis microscópica

Publicado enReumatología
Policondritis recidivante
La policondritis recidivante es una enfermedad rara y compleja, caracterizada por una inflamación recurrente y destructiva que afecta principalmente al cartílago en diversas partes del cuerpo, incluidas las orejas, la…